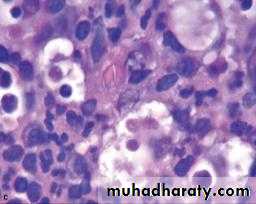

PERIAPICAL DISEASES
Dr asmaa s
Apical PeriodontitisIs the inflammation of the periodontal ligament around the root apex.
There may be resorption of the periapical bone and sometimes the root apex.
May be acute or chronic.Etiology:
• Infection: caries pulpitis pulp death periodontitis.• Trauma:
• Direct blow damaging the apical vessels.
• High filling, biting on hard object in food.
Definition: an acute suppurative process of the dental periapical region.
Usually arises as a result of:
• Infection: following pulpitis, or hematogenous spread.• Traumatic injury.
• Pulp necrosis.
• Mechanical/chemical manipulation in R.C.T.
• More commonly, it originates in an area of chronic infection; e.g.: periapical granuloma .
Acute apical periodontitis /Acute periapical abscess (dentoalveolar abscess)
Clinical features:History of pain due to previous pulpitis.
A large carious cavity or filling is usually present.
Thermal stimulation doesn’t cause pain.
When periodontitis develops, escape of exudate into PDL causes the tooth to be:
• extremely painful.
• extremely sensitive to percussion.
• slightly extruded from its socket.
As pus starts to form, pain becomes intense & throbbing in character.
• Incipient stage:
• Local vasodilatation stagnation of blood exudate elevated intraperiapical pressure the tooth feels elongated• Biting on the tooth relieves pain because it pushes fluids away.
• Advanced stage :
• Persistant pressure stretches periodontal ligament fibers pain
• Constant increase in pressure activates osteoclastic formation bone resorption. PMNs release proteolytic enzymes pus and abscess formation.
• Pain intensity increases tooth becomes tender to percussion and even touch.
• Pus seeks a pathway of least resistance through alveolar bone.• Additional feeling of elongation and fullness.
• As pus penetrate outer cortical plate pain is lowered and swelling appears.
Acute periapical abscess:
Radiographic features:
Initially, No radiographic change.
With progression, slight widening of PDL, lamina dura may become less defined.Histopathological features:
Abscesses show dense, almost solid masses of neutrophils (pus cells) often inter- mixed with inflammatory exudate, cellular debris, necrotic material, bacterial colonies.Inflammatory cells infileterate , cellular debris with necrotic materials , ect.
Histopathological featuresWhat are the sequels if not treated?
• purulence bone through the medullary spaces resulting in: *osteomyelitis.
The purulent may spread diffusely through the overlying soft tissue as *cellulitis.
•The purulent may collect and find a way to the outside through a:
*sinus opening:- Intaorally:
- Extraorally on the skin surface :
(Cutaneous sinus).
accumulation in the CT overlying the bone and can create a sessile swelling .
Treatment:
Incision and drainage.Treatment of offending tooth.
• Chronic Apical Periodontitis(Periapical granuloma)
Chronic Apical Periodontitis(Periapical granuloma)Low-grade infection.
One of the most common of all sequelae of pulpitis or acute periapical periodontitis.
Periapical granulomas represent approximately 75 % of apical inflammatory lesions and 50 % of those that have failed to respond to conservative endodontic measures.
A mass of chronically inflamed granulation tissue at the apex of a nonvital tooth.
It may arise from:
1- Low grade pulpitis.2- Infection through the gingival crevice.
3- Trauma.
4- Haematogenous infection.
Not static may transform into periapical cysts or may demonstrate acute exacerbations with abscess formation.
Clinical Features:
The involved tooth is usually nonvital and may be slightly tender to percussion.Patients may complain of mild pain on biting or chewing on solid food.
The tooth feels slightly elongated in its socket.
Rarely presents severe clinical features.
many cases are entirely asymptomatic.
Radiographic Features:
Most lesions are discovered on routine radiographic examination.A well-defined radiolucency of bone apical to the offending tooth. Loss of the apical lamina dura.
The lesion may be circumscribed or ill defined.
The size is variable.
Histopathologic Features
Inflamed granulation tissue surrounded by a fibrous connective tissue wall.Dense lymphocytic infiltrate that is intermixed with neutrophils, plasma cells and giant cells.
Epithelial rests of Malassez may be identified within the granulation tissue.
Collections of cholesterol clefts with associated multinucleated giant cells.Areas of red blood cell extravasation with hemosidrin pigmentation may be present.
Complications
• Granuloma may continue to enlarge asymptomatically with continued bone and/or root resorption.• Suppuration and formation of an acute periapical abscess.
• Proliferation of epithelial rests of Malassez and formation of a radicular cyst.
• Sometimes bone apposition may occur instead of resorption (osteosclerosis, condensing osteitis).
• Hypercementosis.
Apical Periodontal Cyst(Radicular cyst, periapical cyst, root end cyst)
The apical periodontal cyst is the most common odontogenic cyst encountered in a dental clinic.It is the usual sequele of the periapical granuloma originating as a result of bacterial infection and necrosis of the dental pulp, nearly always following carious involvement of the tooth.
The epithelial lining is derived from the epithelial rests of Malassez, which proliferate as a result of the inflammatory stimulus in a pre-existing granuloma.
OR it may be derived in some cases from:
Respiratory epithelium of the maxillary sinus when the periapical lesion communicates with the sinus wall.
Oral epithelium from a fistulous tract.
Oral epithelium proliferating apically from a periodontal pocket.
Clinical Features:
The majority are asymptomatic.20 and 60 years.
The tooth is non-vital and is seldom painful or even sensitive to percussion.Rarely produce expansion of the cortical plates.
Cyst of long standing may undergo an acute exacerbation which lead to abscess formation.Radiographic Features.
in most cases is identical to periapical granuloma,but, the cyst may be of greater size than the granuloma.Occasionally the apical periodontal cyst exhibits a thin, radiopaque line around the periphery of the radiolucent area, and this indicates a reaction of the bone to the slowly expanding mass.
Histological Features.
Histological Features.The epithelium lining the apical periodontal cyst is usually stratified squamous in type .
The only exception are periapical cyst of maxillary teeth that involve the maxillary sinus.
In occasional instances the cyst may then be lined with a pseudostratified ciliated columnar or respiratory type of epithelium.
The usual squamous epithelium seldom exhibits keratin formation.
This lining epithelium varies remarkably in thickness.
During active growth the capsule is vascular and infiltrated by chronic inflammatory cells adjacent to the proliferating epithelium.
Hyaline bodies may be seen in the epithelium and mucous cells are often present as a result of metaplasia.
Long-standing cysts typically have a thin flattened epithelial lining, a thick fibrous wall and minimal inflammatory infiltrate.
The capsule consists of collagenous fibrous connective tissue.
In a bony wall there is osteoclastic activity and resorption.Beyond the zone of resorption these is usually active bone formation.The net effect is that a cyst expands but retains a bony wall, even after it has extended beyond the normal bony contours.
Within the cyst capsule there are often areas split up by fine needle-shaped clefts.These are left by cholesterol dissolved-out during preparation for sectioning.The cholesterol is derived from breakdown of blood cells.